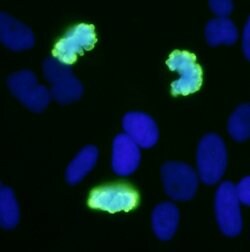
Phospho-Histone H3 (Ser10) Rabbit anti-Human, Mouse, Polyclonal, Bethyl

Learn More
Phospho-Histone H3 (Ser10) Rabbit anti-Human, Mouse, Polyclonal, Bethyl Laboratories

Description
The recommended shelf life for this product is 1 year from date of receipt. Application Note: For ICC, formaldehyde fixation and permeabilization with Triton-X 100 is recommended. Acetone fixation may adversely effect staining. For IHC, epitope retrieval with citrate buffer pH 6.0 is recommended for FFPE tissue sections. Based on 100% sequence identity, this antibody is predicted to react with Rat, D. melanogaster, Zebrafish, X. laevis, X. tropicalis, Chicken, Bovine, Rabbit, Pig and Orangutan
Specifications
Specifications
| Antigen | Phospho-Histone H3 (Ser10) |
| Applications | Flow Cytometry, Immunocytochemistry, Immunofluorescence, Immunohistochemistry, Western Blot |
| Classification | Polyclonal |
| Concentration | 0.2 mg/ml |
| Conjugate | Unconjugated |
| Formulation | TBS with 0.1% BSA and 0.09% sodium azide |
| Gene | HIST1H3A |
| Gene Accession No. | P68431, P68433 |
| Gene Alias | Histone H3, Histone 1, H3a, Histone H3.1, histone H3/a, HIST1H3A |
| Gene Symbols | H3c1, HIST1H3A |
| Show More |
By clicking Submit, you acknowledge that you may be contacted by Fisher Scientific in regards to the feedback you have provided in this form. We will not share your information for any other purposes. All contact information provided shall also be maintained in accordance with our Privacy Policy.